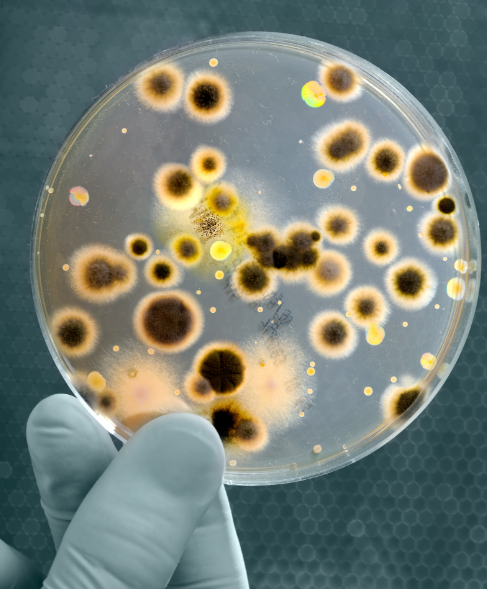

生活中,很多人都有一个误区,觉得冰箱是“保险箱”,食物放进去就不会坏、不会滋生细菌。但恰恰是这种认知,让隐藏在冰箱里的“隐形杀手”——李斯特菌,有了可乘之机。
李斯特菌到底是怎么回事?有哪些注意事项?
“冰箱隐形杀手”
李斯特菌
李斯特菌,全称单核细胞增生李斯特菌(Listeria monocytogenes),是一种广泛存在于自然界中的食源性致病菌,也是病死率最高的食源性致病菌之一。
相较于其他的食源性致病菌,李斯特菌有一个独特之处是“耐寒”,它是常见食源性致病菌里最具风险的嗜冷菌,可在 4℃ 冷藏条件下生长繁殖,在 -20℃ 可存活一年,因此也被称为“冰箱隐形杀手”。
李斯特菌不仅生命力极强,藏身范围也非常广,不光是土壤、水、植物中都可能有它的身影,日常食用的真空包装熟食(香肠、火腿)、未经消毒的生鲜奶、沙拉、果切、机打冰激凌,甚至未彻底清洗的生蔬菜,都可能被它污染。
尤其需要注意的是哈密瓜,它比其他水果更容易被李斯特菌污染。因为下雨时土壤中的细菌容易溅到这些近地面生长的果蔬上,再加上哈密瓜的果皮纹路比较多,清洗的时候很难完全洗干净,切瓜时就可能污染果肉。

高危人群务必当心!
李斯特菌感染主要分两种类型:
肠道型感染
这类感染潜伏期很短,一般在食用被污染食物后的 8~48 小时发病。大多表现为发热、肌肉酸痛、恶心、呕吐等肠胃不适,症状相对轻微,一般几天内便可自行痊愈。
侵袭型感染
这类感染相当危险,而且潜伏期还特别长,可达 2~12 周。
病菌会突破肠道屏障,侵入人体血液循环与神经系统,引发严重的败血症、脑膜炎。这类感染整体发病率不高,但病死率高达30%~70% 。

李斯特菌是一种细胞内寄生菌,人体主要靠细胞免疫功能对其进行清除,所以对于免疫力正常的健康成年人,感染后大多没有明显症状,即便出现不适,也多是轻微的急性肠胃症状或流感样症状,比如发热、恶心、呕吐、腹泻、关节疼痛、肌肉酸痛等,通常具有自限性,几天内可自行痊愈,很难让人联想到是李斯特菌感染。
但对于孕妇、新生儿、65岁以上老人、免疫力缺陷者等免疫力低下人群,感染则可能非常凶险。尤其是孕妇,孕妇感染李斯特氏菌本人可能只会表现出轻微感冒症状,但却能引起胎儿感染,造成胎停、流产等严重后果,据统计约 1/3 的感染孕妇会发生流产。
新生儿、老人及免疫力缺陷者,感染后易引发脑膜炎、败血症、脑炎等严重病症,常出现高热、头痛、意识模糊、呼吸及循环衰竭等症状,病情严重时可危及生命。
防范李斯特菌
只需做到这几点
李斯特菌虽凶险,但并非无懈可击——李斯特菌不耐热,在70℃ 的环境下加热 5 分钟,就能将其彻底灭活。

生活中,只要做好下面这几点,就能有效防范李斯特菌,高危人群,一定要严格执行:
定期清洁冰箱、生熟分开
每 2-3 个月彻底清洁一次冰箱,避免细菌滋生。存放食物时,要注意生熟分开,生肉、禽肉、海产品与即食食品(比如剩菜、水果、熟食)分开放置,用密封容器或保鲜膜隔离,防止交叉污染。
缩短剩菜存放时间
务必彻底加热再食用
剩菜剩饭要在室温 2 小时内放入冰箱冷藏,存放时间最好不超过 24 小时,尽量当天吃完。肉类避免反复解冻,解冻后及时烹饪。
从冰箱取出的熟食、剩菜,一定要彻底加热后再食用,肉类、海鲜、鸡蛋等要加热至中心温度≥70℃ ,持续 2 分钟以上,不要图方便吃冷食或半熟食物。
高危人群
从源头避免感染风险
孕妇、老人、新生儿及免疫力低下者,要尽量避免食用以下食物,从源头降低感染风险:
• 未经巴氏消毒的生鲜奶、软奶酪;
• 真空包装的即食熟食(如香肠、火腿、熏肉),若食用需彻底加热;
• 机打冰激凌、预切水果、凉拌菜、沙拉;
• 未彻底清洗的生蔬菜、生肉、生海鲜;
• 存放时间过长的剩菜剩饭,尤其是绿叶菜。
养成良好生活习惯
处理生食后,一定要用肥皂或洗手液彻底洗手,避免手上的细菌污染其他食物。处理生食和熟食的砧板、刀具要分开,使用后及时洗净、晾干,避免交叉污染。
生食果蔬要彻底清洗,尤其是瓜类,切开后尽快食用或冷藏,不要放置过久。
吃东西前后,一定要用肥皂或洗手液彻底洗手。
如果出现发热、寒战、头痛、恶心、呕吐等症状,特别是高危人群,且近期食用过冷藏食物或高风险食物,一定要及时就医,主动告知医生相关饮食史,避免延误治疗。